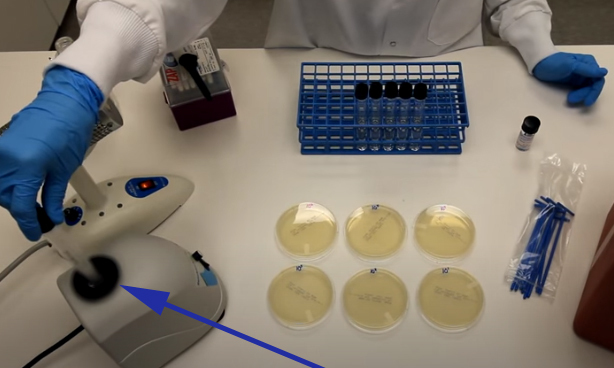
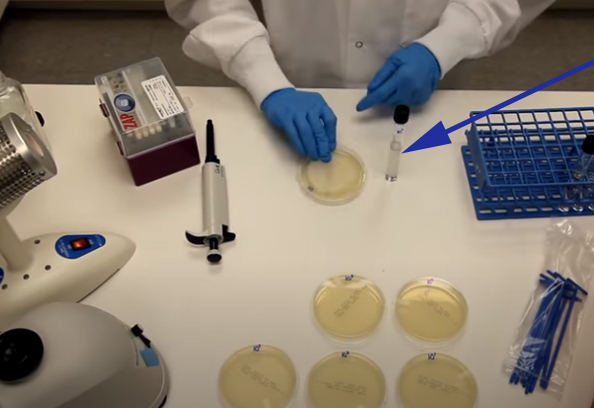

The tube on the right represents a (BLANK) mL dilution tube.
A) 9
B) 6
C) 10
D) 3

Correct Answer:
A) 9
What is the scientific notation being represented?
A) 10
B) 1,000
C) 100
D) 10,000

Correct Answer:
D) 10,000
What is the final dilution in this example?
A) 350 CFU/ML
B) .35 CFU/ML
C) 35 CFU/ML
D) 3.5 CFU/ML

Correct Answer:
C) 35 CFU/ML
How will these plates be labeled?
A) No need to label these
B) Names of the bacteria being used
C) Petri dish 1, 2, 3 etc…
D) Dilution concentrations

Correct Answer:
D) Dilution concentrations
What is the purpose of this step?
A) To separate the water from the microorganisms
B) To mix the dna
C) To achieve a homogeneous suspension
D) To achieve a non-homogeneous suspension
Correct Answer:
C) To achieve a homogeneous suspension
What is the name of the instrument being shown by the arrow?
A) Inoculation pipe
B) Pipette
C) Hypernatremia
D) Inoculation loop

Correct Answer:
B) Pipette
How much is being measured here from each test tube?
A) 3 ML
B) 1 ML
C) 2 ML
D) 4 ML
Correct Answer:
B) 1 ML
What is the purpose of this step?
A) To mix the bacteria with the agar
B) To distribute the inoculum randomly
C) To destroy the bacteria
D) To distribute the inoculum evenly

Correct Answer:
D) To distribute the inoculum evenly
For how long are theses plate placed in an incubator?
A) 2 hours
B) 30 minutes
C) Overnight
D) 2 days

Correct Answer:
C) Overnight
What is the ultimate reason for serial dilutions?
A) To destroy the majority of microorganisms
B) All of these
C) To add water to a pathogen
D) Ability to count the bacterial colonies

Correct Answer:
D) Ability to count the bacterial colonies
What is this ingredient being shown here by the arrow?
A) Jello
B) Agar
C) Carbohydrates
D) Plastic

Correct Answer:
B) Agar
How many ml of water are placed in this mixture?
A) 330
B) 33
C) 3330
D) 3300

Correct Answer:
A) 330
What is the next step?
A) Pour this mixture into another beaker
B) Place this mixture into a microwave
C) Continue mixing this mixture until it turns red
D) Pour this mixture into a petri dish

Correct Answer:
B) Place this mixture into a microwave
Approximately how much time is needed for these to solidify?
A) 2 hours
B) 10 minutes
C) 30 minutes
D) 1 hour

Correct Answer:
D) 1 hour
What is occurring during this step?
A) Collecting fingerprints from the door handle
B) Cleaning the door handle
C) Collecting bacteria from the door handle
D) None of these

Correct Answer:
C) Collecting bacteria from the door handle
How long do these petri dishes need to stay in this closed box?
A) 4 days
B) 1 day
C) 7 days
D) 14 days

Correct Answer:
C) 7 days
From which sample is this?
A) One cannot tell
B) Sink
C) Door knob
D) Refrigerator

Correct Answer:
A) One cannot tell
(BLANK) can be used instead of agar to grow bacteria.
A) Phosphorus
B) Salt
C) Gelatin
D) Water

Correct Answer:
C) Gelatin
What does this bacterial growth represent?
A) Microwave
B) Dog water
C) Refrigerator
D) Mouth

Correct Answer:
B) Dog water
The average bacteria is (BLANK) um in size.
A) 1
B) 2
C) 20
D) 10

Correct Answer:
B) 2


